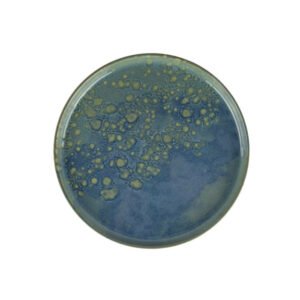
MAGIC FLAT PLATE D17CM STONEWARE ACCOLADE

HOME /

Explore and purchase high-quality crockery online at Restofair RAK. Our collection includes elegant dinnerware, plates, bowls, and more, perfect for enhancing your dining experience. Find durable and stylish crockery for every occasion.
Showing 417–448 of 769 results